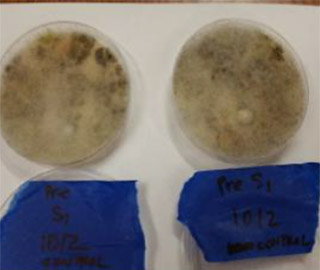
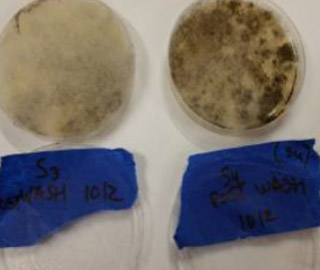
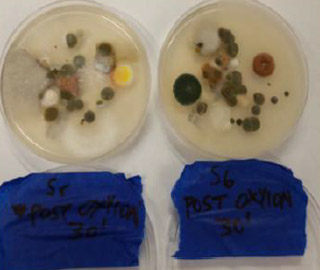
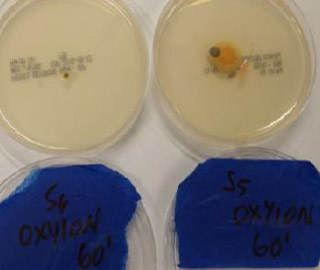

Contamos con el equipo suficiente para satisfacer sus necesidades de logística y carga, siempre a la vanguardia para adecuarnos a las necesidades que nuestros clientes necesiten.
Se implementa un sistema de nueva generación de controles PREVENTIVOS de la contaminación en la cadena de frío
Los beneficios son
S1-2 Pretratamiento 1 Prelavado.
Las muestras se tomaron con el remolque del camión "tal cual" sin limpiar ni lavar.
S3-4 Pretratamiento 2 Prelavado.
Las muestras se tomaron con el remolque del camión después de un lavado normal con agua, detergente y agentes de limpieza habituales utilizados por la Empresa.
S5-6 Pretratamiento 1 Prelavado.
S5-6 Post-tratamiento 1 - OXYION durante 30 minutos. Se tomaron muestras después de poner Oxyion en el remolque y dejarla continuamente durante 30 minutos. El olor desagradable fue neutralizado según las personas presentes durante esta prueba.
S3-4 Pretratamiento 2 Prelavado.
S7-8 Post Tratamiento 2 - OXYION durante 60 minutos. Se tomaron muestras después de poner Oxyion en el remolque y dejarla operar continuamente durante 60 minutos. El olor desagradable ya no estaba presente según las personas presentes durante esta prueba.